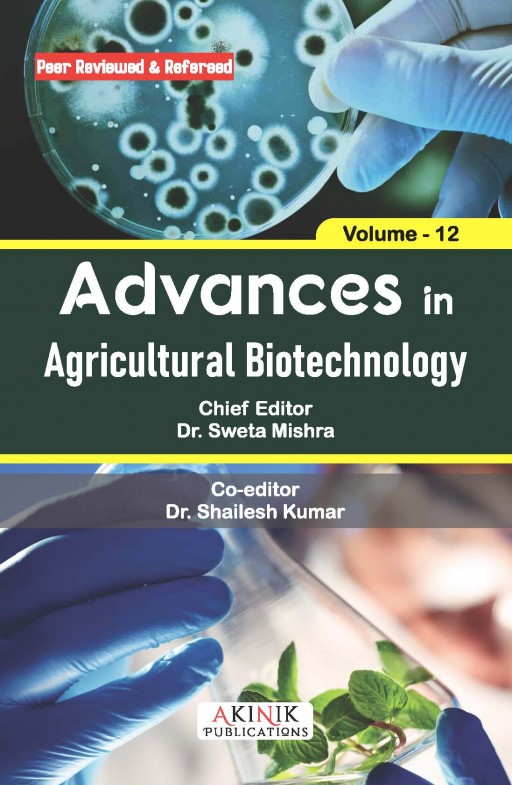
Advances in Agricultural Biotechnology (Volume - 12)

The book entitled "Advances in Agricultural Biotechnology (Volume - 12)" is edited by Dr. Sweta Mishra and Dr. Shailesh Kumar.
The content of the book is as follows:
- Vegetable Crops as Bioreactors for the Production of Edible Vaccines Vegetable Crops as Bioreactors for the Production of Edible Vaccines
- Climate Resilient Crops and Sustainable Agriculture
- Innovations in Biotechnology: Exploring the Future of Genetic Engineering
- Characterization of Different Biochemical Parameters in Chickpea (Cicer arietinum L.) Genotypes
- Potential of Plant Growth-Promoting Microbes for Mitigating Salinity Stress
- Regeneration of Vtis vinifera (L) via Organogenesis from Nodal Segments
- Micro Boost for Seeds: Enhancing Quality and Longevity with Micronutrients
- Apical Root Cuttings (ARC): Potato Propagation
- Role of Biotechnology in Vegetable Grafting for Mitigating Biotic and Abiotic Stress